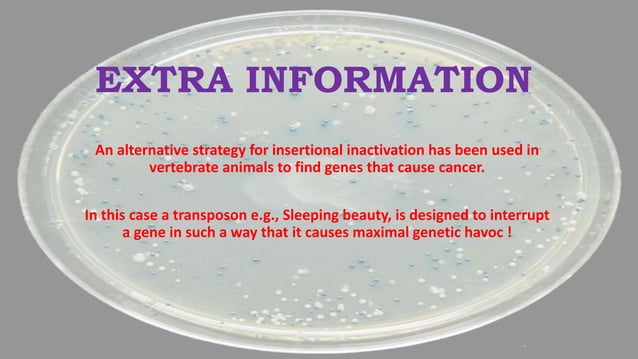
Insertional inactivation

In addition to the information above, here is a curated collection of images related to What Is Insertional Inactivation How It Helps In The Selection Of.
- INSERTIONAL INACTIVATION AND COMPLEMENTATION OF DEFINED MUTATION (1).Pptx
- Genetic Selection And Insertional Inactivation | PDF
- Insertional Inactivation
- Insertional Inactivation | PPT
- Solved Insertional Inactivation Is One Of The Key Features | Chegg.Com
Find More About "What Is Insertional Inactivation How It Helps In The Selection Of"
Explore exclusive offers, detailed information, and related services about what is insertional inactivation how it helps in the selection of from our trusted partners.
View Special Offers